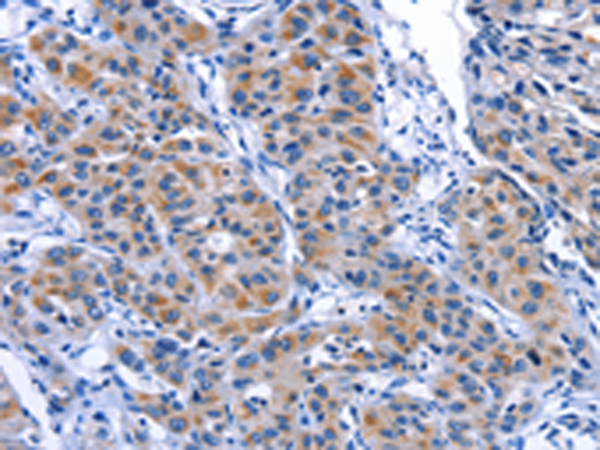
一抗

中文名稱: 兔抗MYH1多克隆抗體
英文名稱: Anti-MYH1 rabbit polyclonal antibody
別 名: MYHa; MYHSA1; MyHC-2x; MyHC-2X/D
抗 原: MYH1
儲 存: 冷凍(-20℃)
宿 主: Rabbit
相關類別: 一抗
反應種屬: Human, Mouse
標 記 物: Unconjugate
克隆類型: rabbit polyclonal
技術規(guī)格
|
Background: |
Myosin is a major contractile protein which converts chemical energy into mechanical energy through the hydrolysis of ATP. Myosin is a hexameric protein composed of a pair of myosin heavy chains (MYH) and two pairs of nonidentical light chains. Myosin heavy chains are encoded by a multigene family. In mammals at least 10 different myosin heavy chain (MYH) isoforms have been described from striated, smooth, and nonmuscle cells. These isoforms show expression that is spatially and temporally regulated during development. |
|
Applications: |
ELISA, IHC |
|
Name of antibody: |
MYH1 |
|
Immunogen: |
Fusion protein of human MYH1 |
|
Full name: |
myosin, heavy chain 1, skeletal muscle, adult |
|
Synonyms: |
MYHa; MYHSA1; MyHC-2x; MyHC-2X/D |
|
SwissProt: |
P12882 |
|
ELISA Recommended dilution: |
2000-5000 |
|
IHC positive control: |
Human lung cancer and human colon cancer |
|
IHC Recommend dilution: |
25-100 |

 購物車
購物車 幫助
幫助
 021-54845833/15800441009
021-54845833/15800441009